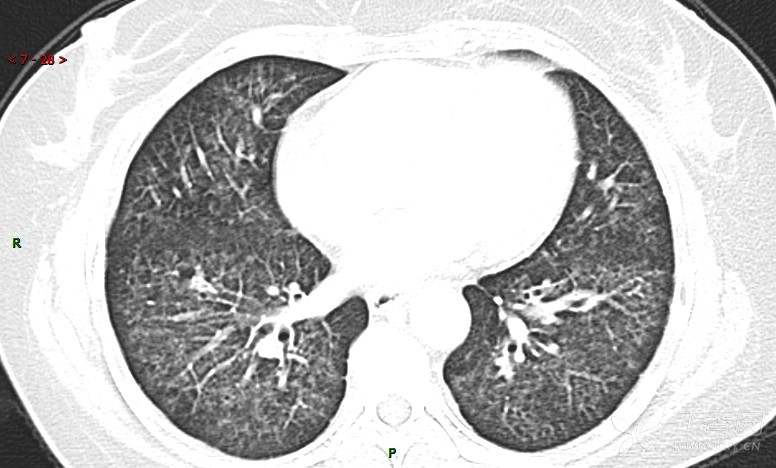
img
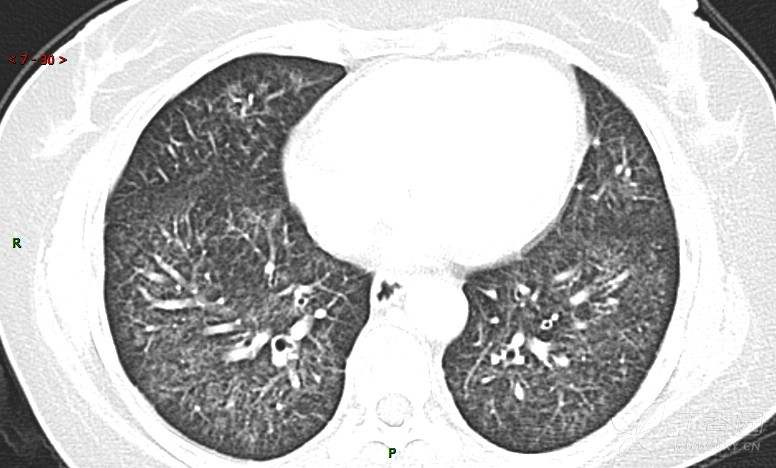
img

肺内弥漫性网状结节影,PET-CT却无阳性病灶,这是?(附其他2例链接)
华夏览雄 达人已点赞原帖名:病例三连发,重在讨论啊
女性,58岁,阵发性咳嗽2月,加重1月。
患者于2月前无明显诱因出现咳嗽,以阵发性干咳为主,接触冷空气后咳嗽明显,偶咳少量白色泡沫样痰,咳嗽剧烈时感憋喘,无发热、盗汗,无头痛、头晕,无胸痛、咯血,无恶心、呕吐,无腹痛、腹泻,无尿频、尿痛等不适,于当地医院给予肌注及静脉药物治疗,具体药物名称不详,效果欠佳,近1月来患者咳嗽频率较前增加,咳嗽剧烈时感双侧季肋区疼痛不适,10余天前出现发热,体温在38℃左右,伴畏寒、寒战,无头痛、头晕,无纳差、乏力等不适,药物治疗后体温降至正常,仍阵发性咳嗽,今为求进一步诊治,就诊于我院急诊,因呼吸内科暂无床位,急诊门诊以“肺间质病变”收入急诊留观室,给予“抗感染、止咳”等对症支持治疗后,今日以“肺间质性病变”收入我科,患者自本次发病以来,神志清,精神可,饮食尚可,睡眠一般,大小便正常,体重较前无明显变化。
平素身体一般,既往“慢性支气管炎”病史30余年,近18年未急性发作,否认高血压、冠心病、糖尿病等慢性疾病病史,无乙肝、肺结核病史及其密切接触者,无手术史,无外伤史,无血制品输入史,患者自诉近日静脉用药后出现皮疹、红斑等不良反应,详细询问患者及其家属均无法提供具体药物过敏药物信息,预防接种史随当地。
糖类抗原15-3 70.7 U/ml ↑ 0--31.3
癌胚抗原 57.12 ng/mL ↑ 0--5
糖抗原125 166.8 U/ml ↑ 0--35
细胞角蛋白19片段测定 8.32 ng/ml ↑ ≤3.3
糖抗原199 901.79 U/ml ↑ 0--37
AFP、NSE(-)
患者活检肺组织后行PET/CT检查



请讨论